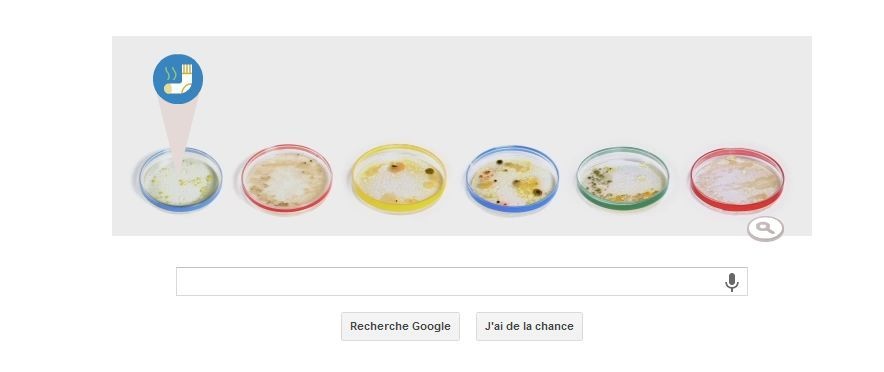

Le salon du e-commerce se déroule à Paris et les articles ou études concernant la vente en ligne se multiplient ces derniers jours.
Du 24 au 26 Septembre se déroule le salon du ecommerce à Paris.
A cette occasion, nombreuses sont les publications reprenant les tendances du moments, compilant les solutions ou encore évoquant les innovations à venir.
Parmi tout ces post, blog, et autres conférences, la société Kantar Media à publié un récapitulatif très instructif à notre goût, repris et diffusé par le journal du net (JDN )
Il s'agit des données moyennes du fameux taux de transformation aussi appellé Taux de Conversion, d'un site de vente en ligne, catégorie par catégorie, domaine par domaine.
Le Taux de transformation est le fameux graal que chaque marchand calcule en divisant son nombre de commande(s) par son nombre de visites.
Attention, on parle là de visites et non de visiteurs ( #visiteurs uniques). Celui-ci est exprimé en %, voir en 1 pour 1000 selon les domaines.
C'est ce fameux taux qui surprend toujours les clients de La Boite A Truc qui nous réclament une boutique en ligne pour leur commerce en Corse.
Sachez que le taux moyen en France est de 0,5 à 2 %
A cette occasion, nombreuses sont les publications reprenant les tendances du moments, compilant les solutions ou encore évoquant les innovations à venir.
Parmi tout ces post, blog, et autres conférences, la société Kantar Media à publié un récapitulatif très instructif à notre goût, repris et diffusé par le journal du net (JDN )
Il s'agit des données moyennes du fameux taux de transformation aussi appellé Taux de Conversion, d'un site de vente en ligne, catégorie par catégorie, domaine par domaine.
Le Taux de transformation est le fameux graal que chaque marchand calcule en divisant son nombre de commande(s) par son nombre de visites.
Attention, on parle là de visites et non de visiteurs ( #visiteurs uniques). Celui-ci est exprimé en %, voir en 1 pour 1000 selon les domaines.
C'est ce fameux taux qui surprend toujours les clients de La Boite A Truc qui nous réclament une boutique en ligne pour leur commerce en Corse.
Sachez que le taux moyen en France est de 0,5 à 2 %
Il était temps que Google nous propose un vrai Doodle animé. Celui du 8 juillet 2013 est particulièrement ludique
Le 8 juillet 1947, un fermier américain (forcément !) du nouveau mexique découvrait des débris qui pouvaient être ceux d'une navette spaciale.
Le bled s'appelle Roswell et va devenir le centre du monde des fantasmes extra terrestre !
Les morceaux de la navette de l'extra terrestre se seraient donc éparpillés au milieu de la ferme.
Le doodle d'aujourd'hui propose de se balader dans la dîte ferme pour retrouver l'ensemble des morceaux et repartir sur sa planète.
Le bled s'appelle Roswell et va devenir le centre du monde des fantasmes extra terrestre !
Les morceaux de la navette de l'extra terrestre se seraient donc éparpillés au milieu de la ferme.
Le doodle d'aujourd'hui propose de se balader dans la dîte ferme pour retrouver l'ensemble des morceaux et repartir sur sa planète.
Enfin un joli Doodle animé réalisé ce 31 mai qui propose des Boites à Trucs animées...les boites de Petri
Joli Doodle animé ce 31 Mai avec la célébration du 161eme anniversaire de l'inventeur des petites boites transparentes.
Ces petites boites ont révolutionné la monde de la recherche et l'étude des bactéries (l'assitant de Petri ayant mis à jour le bacile de Kock grâce a cette transparence)
Ces petites boites ont révolutionné la monde de la recherche et l'étude des bactéries (l'assitant de Petri ayant mis à jour le bacile de Kock grâce a cette transparence)
Il y a quelques semaines, l'équipe de l'émission In Vivo
Christophe Zagaglia consacrait il y a quelques semaines son émission In Vivo au CampusPlex.
Diffusé un dimanche de beau temps (et il n'y en a pas eu tant que ça), certain comme nous n'avaient pas pu écouter les élucubrations de cette équipe remarquable au sein de la laquelle La Boite A Truc a la chance d'évoluer.
Le site de France Bleu vient de mettre à jour ses podcast.
Celui concernant l'émission InVivo diffusée le 07 avril est maintenant disponible
Le lien ci contre vous permet d'écouter ou ré-écouter l'émission : Podcast RCFM Campusplex
Diffusé un dimanche de beau temps (et il n'y en a pas eu tant que ça), certain comme nous n'avaient pas pu écouter les élucubrations de cette équipe remarquable au sein de la laquelle La Boite A Truc a la chance d'évoluer.
Le site de France Bleu vient de mettre à jour ses podcast.
Celui concernant l'émission InVivo diffusée le 07 avril est maintenant disponible
Le lien ci contre vous permet d'écouter ou ré-écouter l'émission : Podcast RCFM Campusplex
Joli sortie pour MSN qui ferme ses portent aujourd'hui avec une jolie vidéo d'adieu
La deuxieme mort de Buddy
Voilààààààà c'est fini.
Terminé MSN depuis...ben maintenant en fait mais sans doute vous aussi depuis très longtemps.
Depuis quand n'aviez vous pas entendu le petit "tututu" ou un "wizzzzzz" énervant.
La Boite A Truc a même vérifié si MSN était encore installé sur nos PC ( oui il en restait encore un peu) mais franchement Skype avait presque fait oublier cet outil phénoménal de Microsoft.
Fini les chat, les dragues ( euh nous c'était à l'ancienne, puis avec des mails...mais c'était il y a si longtemps :) ) et les échanges cachés.
MSN est mort aujourd'hui et Microsoft France lui offre une sortie assez drôle avec cette vidéo à découvrir ici.
Terminé MSN depuis...ben maintenant en fait mais sans doute vous aussi depuis très longtemps.
Depuis quand n'aviez vous pas entendu le petit "tututu" ou un "wizzzzzz" énervant.
La Boite A Truc a même vérifié si MSN était encore installé sur nos PC ( oui il en restait encore un peu) mais franchement Skype avait presque fait oublier cet outil phénoménal de Microsoft.
Fini les chat, les dragues ( euh nous c'était à l'ancienne, puis avec des mails...mais c'était il y a si longtemps :) ) et les échanges cachés.
MSN est mort aujourd'hui et Microsoft France lui offre une sortie assez drôle avec cette vidéo à découvrir ici.
C'est sans doute la meilleure blague Carambar que l'on est lue depuis longtemps.
Voila comment une agence de com nous a amener à pleurer tous ensemble la fin des blagues Carambar dans moins d'un mois.
"Parce qu'en matière d'éducation chaque acte compte, parce que de nombreuses études démontrent que les plus jeunes retiennent mieux en mangeant, parce que Carambar est une marque responsable (...), nous avons décidé de remplacer nos blagues par des exercices ludo-éducatifs", certifie un communiqué de presse reçu à la rédaction.
Puis la page Facebook de la marque s'en mèle, annonçant super gravement un rendez vous à venir "capitale"...concernant les Carambar.
Même le slogan présidentiel y passe avec un fameux "le changement c'est pour maintenant".
Voila comment une agence de com nous a amener à pleurer tous ensemble la fin des blagues Carambar dans moins d'un mois.
"Parce qu'en matière d'éducation chaque acte compte, parce que de nombreuses études démontrent que les plus jeunes retiennent mieux en mangeant, parce que Carambar est une marque responsable (...), nous avons décidé de remplacer nos blagues par des exercices ludo-éducatifs", certifie un communiqué de presse reçu à la rédaction.
Puis la page Facebook de la marque s'en mèle, annonçant super gravement un rendez vous à venir "capitale"...concernant les Carambar.
Même le slogan présidentiel y passe avec un fameux "le changement c'est pour maintenant".
Un joli petit site qui nous a plu tout autant dans le message que par la technique.
Dans nos différentes recherches et veilles techniques ( ça fait tout de suite plus sèrieux que "trouvé par hasard sur un blog de desing") nous sommes tombé il y a quelques temps sur un joli site parlant d'un sujet important à nos yeux.
Et même si la météo de ce dimanche soir ne prête guère à l'inquiétude quand à la quantité d'eau disponible, ce site permet de sensibiliser "un peu" contre le gaspillage permanent d'eau dans les civilisations modernes.
Every Last Drop est donc un site utile !
Mais c'est aussi un joli site du point de vue internet.
Une très belle exploitation de la navigation en scrollant afin de découvrir l'histoire d'une journée type d'un britanique et de sa consomation en eau.
C'est très bien fait, c'est moderne, ludique, eco-citoyen et techniquement très bien réalisé : La Boite A Truc aime !
Ce site à été réalisé pour l'ONG Waterwise dont le site, lui, est particulièrment moche.
Réalisé par l'agence Nice & Serious
Et même si la météo de ce dimanche soir ne prête guère à l'inquiétude quand à la quantité d'eau disponible, ce site permet de sensibiliser "un peu" contre le gaspillage permanent d'eau dans les civilisations modernes.
Every Last Drop est donc un site utile !
Mais c'est aussi un joli site du point de vue internet.
Une très belle exploitation de la navigation en scrollant afin de découvrir l'histoire d'une journée type d'un britanique et de sa consomation en eau.
C'est très bien fait, c'est moderne, ludique, eco-citoyen et techniquement très bien réalisé : La Boite A Truc aime !
Ce site à été réalisé pour l'ONG Waterwise dont le site, lui, est particulièrment moche.
Réalisé par l'agence Nice & Serious
Ce lundi 11 Mars, Google nous propose un joli Doodle animé avec cette fois encore des zones à découvrir.
L'animation célèbre aujourd'hui ce qui aurait été le 61eme anniversaire de l'écrivain de science fiction Douglas Adams, auteur (entre autre) du best seller Le guide du Voyageur Galactique (1979)
Il s'agit d'un roman melant SF et humour, sur le thème d'un voyage post apocalyptique dans l'univers en auto-stop.
Le doodle du jour est donc à découvrir en baladant la souris un peu partout et voir ou entendre le petit robot sortir de l'ascenceur, un lecteur sortir des kilometre de bandeau, des bruitages surprenants et une petite animation "Don't panic".
L'animation célèbre aujourd'hui ce qui aurait été le 61eme anniversaire de l'écrivain de science fiction Douglas Adams, auteur (entre autre) du best seller Le guide du Voyageur Galactique (1979)
Il s'agit d'un roman melant SF et humour, sur le thème d'un voyage post apocalyptique dans l'univers en auto-stop.
Le doodle du jour est donc à découvrir en baladant la souris un peu partout et voir ou entendre le petit robot sortir de l'ascenceur, un lecteur sortir des kilometre de bandeau, des bruitages surprenants et une petite animation "Don't panic".
Follow Murad sur Instangram et ses clichés.
C'est Vendredi, c'est donc jour de blog "moins sérieux" avec le buzz du moment sur Instangram.
En effet, vous les avez sans doute vues passer sur le web, les photos de dos d'une jeune (et charmante) fille tenant visiblement la main du photographe.
Ces photos, prises un peu partout dans les hauts lieux touristiques du monde entier sont l'ouvre de Murad Osmann.
Ce jeune producteur de musique russe prend depuis 2 ans sa fiancé ( et non moins mannequin) en photo dans tous les voyages réalisés par le couple.
Toujours la même pose mais beaucoup de variantes bien-sûr, vestimentaires, géographiques et thématiques...
Les photos sont ensuite diffusées sur Instangram et cela semble vraiment plaire.
Muradosmann est suivi par 111 018 followers.
A découvrir : http://instagram.com/muradosmann/
En effet, vous les avez sans doute vues passer sur le web, les photos de dos d'une jeune (et charmante) fille tenant visiblement la main du photographe.
Ces photos, prises un peu partout dans les hauts lieux touristiques du monde entier sont l'ouvre de Murad Osmann.
Ce jeune producteur de musique russe prend depuis 2 ans sa fiancé ( et non moins mannequin) en photo dans tous les voyages réalisés par le couple.
Toujours la même pose mais beaucoup de variantes bien-sûr, vestimentaires, géographiques et thématiques...
Les photos sont ensuite diffusées sur Instangram et cela semble vraiment plaire.
Muradosmann est suivi par 111 018 followers.
A découvrir : http://instagram.com/muradosmann/
14 Février, alors forcément, on se demande ce que Google va Doodliser.
Un doodle animé
14 Février, Saint Valentin....Google se devait de marquer le coup.
Mais comme Google ne fait jamais les choses comme les autres, ce n'est pas seulement le jour de Cupidon mais aussi le 154eme anniversaire de Georges Ferris, inventeur de la Grande Roue.
Grande Roue utilisée par Google pour illustrer son Doodle de Saint Valentin...pfff sont trop malins !
Mais bon, il est bien caché ce brave Georges.
Mais comme Google ne fait jamais les choses comme les autres, ce n'est pas seulement le jour de Cupidon mais aussi le 154eme anniversaire de Georges Ferris, inventeur de la Grande Roue.
Grande Roue utilisée par Google pour illustrer son Doodle de Saint Valentin...pfff sont trop malins !
Mais bon, il est bien caché ce brave Georges.
Entre communautarisme et sectarisme, le nouveau filon des sites de rencontres sur le net est de trier.
Les geek aussi peuvent faire des rencontres.
Hier, Corse Matin faisait sa une avec les 7000 Corses qui recherchent "l'âme soeur sur le net"
Sans doute en réaction du site Corsica Rencontre dont on parle beaucoup en ce moment ( lire l'article sur Parôle de Corse )
Clairement annoncé comme un site permettant "aux corses" de se rencontrer entre eux, voir avec des "amoureux de la Corse", le site de rencontre insulaire semble surfer sur la nouvelle tendance de ce genre de site : le tri, le tri et encore le tri.
Est-ce donc la fin des mega généralistes comme Meetic, Attractive etc...
Est ce que le coeur (ou le cul) ne peut battre que pour quelqu'un qui nous ressemble.
Sans doute en réaction du site Corsica Rencontre dont on parle beaucoup en ce moment ( lire l'article sur Parôle de Corse )
Clairement annoncé comme un site permettant "aux corses" de se rencontrer entre eux, voir avec des "amoureux de la Corse", le site de rencontre insulaire semble surfer sur la nouvelle tendance de ce genre de site : le tri, le tri et encore le tri.
Est-ce donc la fin des mega généralistes comme Meetic, Attractive etc...
Est ce que le coeur (ou le cul) ne peut battre que pour quelqu'un qui nous ressemble.
Dans quelques jours, Google mettra en ligne une nouvelle refonte de Google Image.
Google Image va bientôt changer d'apparence.
C'est en effet ce que le blog officiel Google annonçait hier avec un certain nombre d'écran pour illustrer ces changements.
Le but de cette refonte est une optimisation des résultats décriés pour le manque de rapidité mais aussi pour l'ergonomie actuelle et l'absence d'informations.
C'est en effet ce que le blog officiel Google annonçait hier avec un certain nombre d'écran pour illustrer ces changements.
Le but de cette refonte est une optimisation des résultats décriés pour le manque de rapidité mais aussi pour l'ergonomie actuelle et l'absence d'informations.
Le blog de La Boite A Truc, Web agency sur Ajaccio.
Création et conception de site web, refonte de site Internet, référencement, gestion du contenu et animation.
Création et conception de site web, refonte de site Internet, référencement, gestion du contenu et animation.